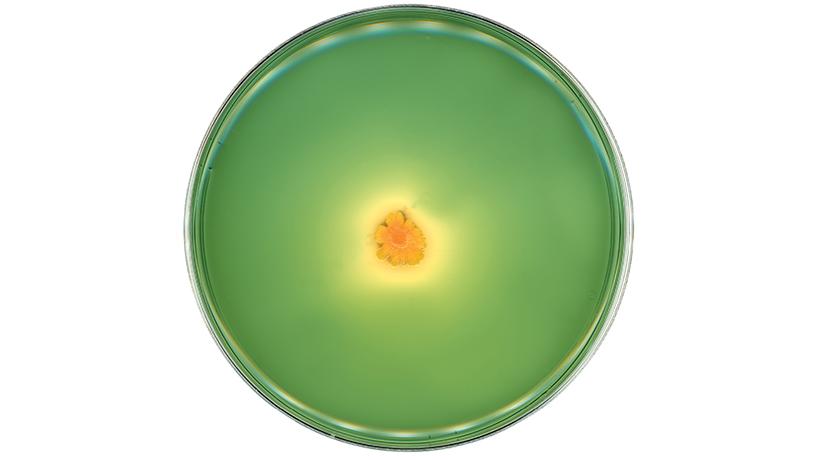
Finding Beauty in the World of Microbes | Biomedical Engineering

マイストア
変更
お店で受け取る
(送料無料)
配送する
納期目安:
2025.11.25 8:20頃のお届け予定です。
決済方法が、クレジット、代金引換の場合に限ります。その他の決済方法の場合はこちらをご確認ください。
※土・日・祝日の注文の場合や在庫状況によって、商品のお届けにお時間をいただく場合がございます。
洋楽 Cleanse the Bacteria - Various Artists Various – Cleanse The Bacteria Compilation, 2xLP (black vinylの詳細情報
Various – Cleanse The Bacteria Compilation, 2xLP (black vinyl。Various – Cleanse The Bacteria Compilation, 2xLP (black vinyl。The Miraculous Beauty and Healing Power of Ordinary Bacteria。スケートロックの名作、パスヘッドのアートワークが特徴的なレコードです。jazz ジャズ レコードセット 6枚 blue note 他。素人保管です。d*3様 Prince プリンス / 1978-1984 レコード。Liberty Science Center :: Microbes Rule!。- タイトル: Cleanse the Bacteria- アーティスト: Various Artists- ジャンル: Skate Rock- レコードの状態: 良好ご覧いただきありがとうございます。ソノシート付きです。Lana Del Rey - Did You Know… レコード。【mynameis2021】ウェザーリポートサイン入りLPレコード。完璧な物を求められている方はご遠慮ください。ハードコアパンクpushead
ベストセラーランキングです
近くの売り場の商品
カスタマーレビュー
オススメ度 4.2点
現在、7742件のレビューが投稿されています。